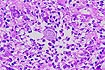
Siehe Vergroesserung 9,24

Abb.9,1 Histoplasmose
|
 Abb.9,2 Histoplasmose
|
 Abb.9,3 Histoplasmose
|
 Abb.9,4 Histoplasmose
|
 Abb.9,5 Histoplasmose
|
 Abb.9,6 Histoplasmose
|
 Abb.9,7 Histoplasmose
|
 Abb.9,8 Histoplasmose
|
 Abb.9,9 Histoplasmose
|
 Abb.9,10 Histoplasmose
|
 Abb.9,11 Histoplasmose
|
 Abb.9,12 Histoplasmose
|
 Abb.9,13 Histoplasmose
|
 Abb.9,14 Histoplasmose
|
 Abb.9,15 Histoplasmose
|
 Abb.9,16 Histoplasmose
|
 Abb.9,17 Histoplasmose
|
 Abb.9,18 Histoplasmose
|
 Abb.9,19 Histoplasmose
|
 Abb.9,20 Histoplasmose
|
 Abb.9,21 Histoplasmose
|
 Abb.9,22 Histoplasmose
|
 Abb.9,23 Histoplasmose
|
Abb.9,24 Histoplasmose
|
 Abb.9,25 Histoplasmose
|
 Abb.9,26 Histoplasmose
|
 Abb.9,27 Histoplasmose
|
 Abb.9,28 Histoplasmose
|
 Abb.9,29 Histoplasmose
|
 Abb.9,30 Histoplasmose
|
 Abb.9,31 Histoplasmose
|
 Abb.9,32 Histoplasmose
|
 Abb.9,33 Histoplasmose
|
 Abb.9,34 Histoplasmose
|
 Abb.9,35 Histoplasmose
|
 Abb.9,36 Histoplasmose
|
 Abb.9,37 Histoplasmose
|
 Abb.9,38 Histoplasmose
|
 Abb.9,39 Histoplasmose
|
 Abb.9,40 Histoplasmose
|
 Abb.9,41 Histoplasmose
|
 Abb.9,42 Histoplasmose
|
 Abb.9,43 Histoplasmose
|
 Abb.9,44 Histoplasmose
|
 Abb.9,45 Histoplasmose
|
 Abb.9,46 Histoplasmose
|
 Abb.9,47 Histoplasmose
|
 Abb.9,48 Histoplasmose
|
 Abb.9.49 Histoplasmose
|
 Abb.9,50 Histoplasmose
|
 Abb.9,51 Histoplasmose
|
 Abb.9,52 Histoplasmose
|
|